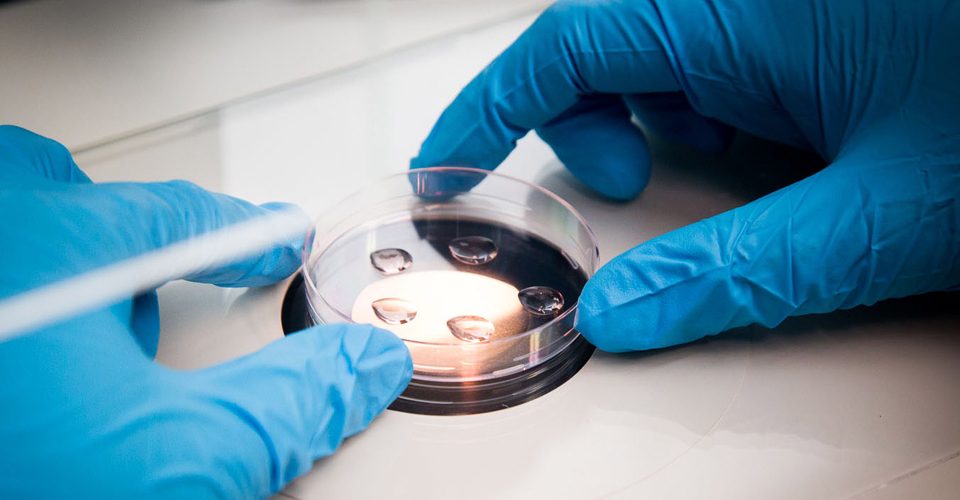

UniBiosys, one of the well equipped biotech research laboratory with an excellent molecular biology platform, provide all-in-one solution to facilitate in-house research projects, Academic research projects and training as per International quality protocols. Our technical team consists of Microbiologists, Bioinformatician, Molecular biologist, Geneticist etc.

Induction of mutations in bacteria for screening of beneficial enzymes and genome analysis. Molecular techniques are applied to gain insight in the biochemical and genetic adaptation of selected processes in Bacteria. UniBiosys offers Microbial & Molecular testing services and Biochemical evaluation of microorganisms.

The process of developing crop varieties is complex and takes time. Future progress of crop
improvement depends largely on the adaption of genomic technologies. The tremendous progress in mapping
agronomically useful genes over the past two decades offers an opportunity to apply the molecular genetics
tools directly in plant breeding.

Marine biotechnology encompasses the efforts that involve the marine resources of the world, either as the source or target of biotechnology applications. The Marine Biology Research investigates the microbiology and physiology of marine organisms, isolation of their secondary metabolites, toxins, anti-toxic substances, bacteria with probiotic properties etc.

Information gathering and knowledge discovery is the latest challenge in modern biology. Genomic information retrieval, better understanding of disease mechanism and novel drug discovery solutions has made possible through bioinformatics approaches. A wide range of research services are offered by UniBiosys for the pharmaceutical/Biotech/Life science industries.
The presence of vast patient population with diverse diseases provides an enormous diagnostic research opportunity. We collaborate with various clinical research organizations on contractual research basis to develop and introduce diagnostic tests.